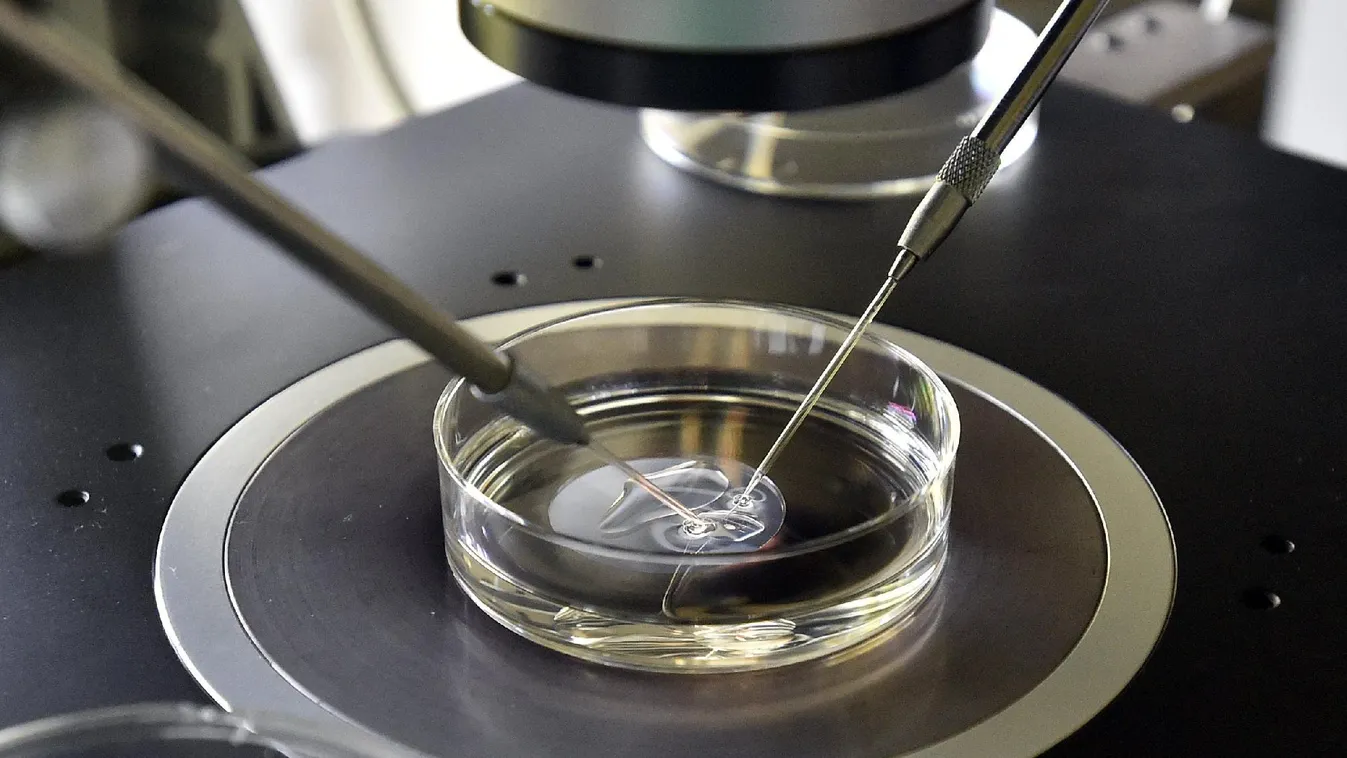
Lombikügy: népszerű vagy elvhű legyen az egyház?

Keresés
Cikk típusa
Rovatok
Műsor szerint
Dátum tartomány
katolikus:
1-10 cikk megjelenítése a(z) 13-ből a keresett kifejezésre


Ferenc pápa: Isten, áldd meg a magyart!

Bejelentést tett a Vatikán Ferenc pápa őszi útjairól

Ételadományokkal járulhatnak a hívek a böjti időszakhoz

Először áll katolikus miniszterelnök az észak-írországi kormány élén + videó

Megkezdődtek a házszentelések a katolikus egyházban
Lombikügy: népszerű vagy elvhű legyen az egyház?

Ferenc pápa nyitottságot vár az egyháztól Ázsiában

Szabadtéri szentmisével búcsúzott a HungaRio











